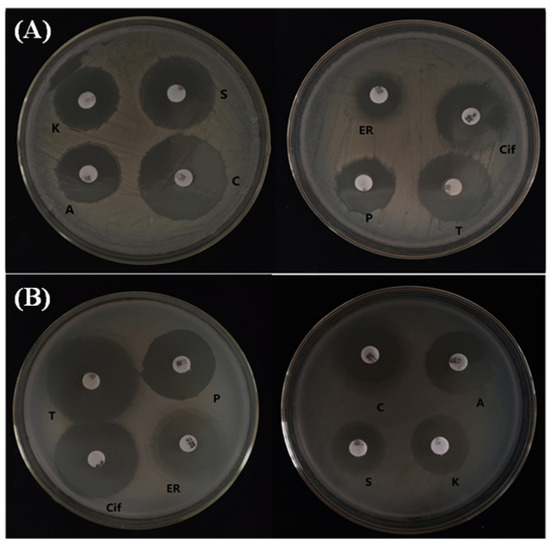

Abstract
Fire blight, a devastating disease caused by Erwinia amylovora, poses a significant threat to pear and apple trees in Xinjiang province, China. In an effort to combat this pathogen, we isolated 10 bacteria from various components of apple and crabapple trees and conducted screenings to assess their ability to inhibit E. amylovora in vitro. Through biochemical tests and partial 16S rRNA gene sequencing, we identified two promising strains, Priestia megaterium strain H1 and Bacillus subtilis strain I2. These strains were then evaluated for their efficacy in biocontrol under controlled laboratory conditions, focusing on immature fruits and leaves. Remarkably, all selected antagonists exhibited the capability to reduce the severity of the disease on both fruit and leaves. P. megaterium strain H1 and B. subtilis strain I2 exhibited significant reductions in disease incidence on both immature fruits and leaves compared to the control. Specifically, on immature fruits, they achieved reductions of 53.39% and 44.76%, respectively, while on leaves, they demonstrated reductions of 59.55% and 55.53%, respectively. Furthermore, during the study, we detected the presence of lipopeptides, including surfactin, iturins, bacillomycin D, and fengycins, in the methanol extract obtained from these two antagonistic bacteria using thin-layer chromatography (TLC). Based on the results obtained, B. subtilis strain I2 and P. megaterium strain H1 exhibit considerable potential for controlling fire blight. However, further evaluation of their efficacy under natural field conditions is essential to validate their practicality as a biocontrol method.
1. Introduction
The bacterial disease fire blight is caused by the Gram-negative bacterium Erwinia amylovora [1]. Members of the subfamily Maloideae, particularly rosaceous plants like apple (Malus spp.) and pear (Pyros spp.) are severely afflicted by this disease. In warm and moist conditions, E. amylovora infects the plant hosts through the nectarthodes of the blooms or wounds in the leaves and twigs [2]. Once established in a plant, the bacteria can spread within the plant’s vascular system. As these bacteria accumulate in the xylem, the affected plant parts suffer from blight and ultimately die due to the blockage of water flow. Additionally, the presence of bacterial ooze, which consists of bacteria, polysaccharides, and plant sap, is a distinct characteristic of fire blight and is produced at the sites of infection. The pathogenic bacterium E. amylovora can infect various parts of the plant, including leaves, shoots, rootstocks, and fruits [3].
Insect pollinators and rainfall are the main routes of fire blight transmission [4]. Enterobacterium is a plant pathogen that induces a necrogenic disease. Initially, it manifests as black and necrotic lesions, eventually leading to plant mortality [5]. E. amylovora, the causative agent of this bacterial disease that was initially identified in the United States in the 1870s, has spread to Europe, Asia, Africa, China, and New Zealand [6].
Almost all cultivars of commercial pears and apples are vulnerable to E. amylovora [7]. Streptomycin and oxytetracycline can be used to effectively manage fire blight; however, this method has a risk of pathogenic strains becoming resistant to them [8]. To manage the disease, copper compounds are administered during the flowering stage. Nonetheless, the use of copper proves detrimental to the leaves, exhibiting phytotoxicity, and also leads to fruit irritation [9]. Biological control is particularly an effective strategy due to the significant risk of phytotoxicity and the causal agent’s tolerance to chemicals and antibiotics [10].
Bacteria such as Bacillus subtilis, B. amyloliquefaciens [11,12]. Lactobacillus plantarum [13], Enterobacter sp., and Serratia sp. [14] have demonstrated antagonistic activity against E. amylovora, indicating their potential as agents for controlling fire blight. Various mechanisms of action, including the production of secondary metabolites and competition for nutrients, have been suggested to explain their inhibitory effects on E. amylovora [15,16]. The use of antibiotics in agriculture, and antibiotic-resistant strains in numerous apple and pear growing regions, has evolved As a result, biocontrol agents (BCAs) for the prevention of fire blight have been studied for a long time [17]. BlightBanTM A506 [Pseudomonas fluorescens A506, isolated from leaves of pear trees] and BlightBanTM C9-1 [Pantoea vagans C9-1, isolated from apple stem tissue] are examples of commercial products that are currently available in the market [18].
Antipathogenic bacteria serve to lessen the severity and spread of disease by preventing the pathogen’s growth or competing for resources [19,20]. The antagonist bacteria’s inhibitory effects on E. amylovora are caused in a number of ways. These strategies include making antibiotics, vying for resources and space, causing systemic resistance in the host plant, and secreting enzymes that break down the pathogen’s cell walls [19]. For instance, research has revealed that Pantoea agglomerans (formerly known as Erwinia herbicola) produces Pantocin A, an antibiotic molecule that prevents the growth of E. amylovora [21]. Furthermore, it has been discovered that Pseudomonas fluorescens competes with E. amylovora for resources and space, restricting the pathogen’s growth [22]. Bacillus subtilis has been shown to induce systemic resistance in apple and pear trees, enhancing their defense against fire blight [23].
The potential of these antagonistic bacteria as biocontrol agents in orchard environments has been thoroughly investigated. They can be used as a component of integrated pest management plans to lessen the need for chemical pesticides and their negative environmental effects. Growers can successfully control fire blight and save their fruit crops by utilizing the inhibitory effects of antagonist bacteria [24].
The objective of this study is to explore the potential of endophytic bacteria, specifically P. megaterium and B. subtilis, isolated from apple and crabapple leaves, as antagonists against E. amylovora, a pathogen causing fire blight in these fruits. The study aims to assess the efficacy of these bacterial isolates both in vitro and in vivo as biological control agents (BCAs) against E. amylovora. This research aims to contribute to the sustainable and environmentally friendly approach of using natural antagonists, such as bacteria, particularly Bacillus, to control pests, pathogens, and diseases in plants. By investigating mechanisms like antibiosis, competition, and induced systemic resistance, the study sheds light on the distinct characteristics and behaviors of these bacteria, offering valuable insights into their potential as effective antagonists in various biological contexts.
2. Materials and Methods
2.1. Identification and Isolation of the Bacterium That Causes Fire Blight (E. amylovora C1)
We used as standard strains of E. amylovora C1 isolated by our research group [25]. To nurture and propagate E. amylovora cultures, we employed nutrient agar (NA), which consists of beef extract, peptone, agar, and sodium chloride, with a pH range maintained between 7.2 and 7.4 [26].
Preparation of a Fire Blight Pathogenic Bacterial Suspension
The method outlined by [27] was employed with minor adjustments to revive the E. amylovora C1 strain from the −80 °C freezer, allowing it to reach room temperature. Following this, a small aliquot of bacterial solution was transferred using an inoculation ring onto NA plates and then incubated for 24 h at 28 °C. Subsequently, robust colonies were selected and sub-cultured into a nutrient broth (NB), which was placed on a constant shaker at 28 °C and agitated at 210 rpm for an additional 24 h. Throughout the incubation period, growth was continually monitored to achieve an optical density OD600nm = 1 (approximately 1.0 × 108 CFU/mL).
2.2. Isolation and Identification of Leaves Endophytic Antagonist Bacteria
The methodology described by [28] with slight modification was used to collect leaf samples from healthy apple and crabapple trees at various sites within Shihezi University, Xinjiang Province, China, during May to September of 2022 and 2023. The objective was to procure potential bacterial antagonists for further investigation. Upon collection, leaf samples were either immediately processed or temporarily refrigerated in plastic bags to maintain freshness. Leaf tissue sections were macerated in sterile-distilled water (2–3 milliliters) for 30 min to create suspensions for subsequent analysis. These suspensions were streaked onto NA plates, chosen for their ability to support bacterial growth. Streaking was crucial for isolating potential bacterial antagonists. The NA plates were then incubated at temperatures ranging from 26 to 28 °C for 48–72 h to allow observation and cultivation of bacterial colonies present in the leaf samples, facilitating their subsequent identification and study.
2.3. Antagonist and Pathogenic bacteria (E. amylovora) Screening
The methodology outlined by [14] with slight adjustments involves cultivating bacterial cultures obtained from E. amylovora C1 and leaf samples in a nutrient-rich NB liquid medium (3.0 g/L beef extract, 5.0 g/L peptone, 5.0 g/L NaCl, pH 7.2–7.4) at 28 °C with gentle agitation at 210 rpm. Following a 24 h incubation period, the bacterial suspension was diluted to achieve an optical density OD600nm = 1 (approximately 1.0 × 108–1.0 × 109 CFU/mL).
To assess antimicrobial activity, 300 µL of pathogenic bacterial suspension (approximately 2 × 108 CFU/mL) was spread onto nutrient agar plates and allowed to stand for 5 min. Subsequently, paper discs saturated with antagonistic bacteria suspensions adjusted to around 108 CFU/mL were placed on the plates. The plates were then incubated at 27 °C for 48–72 h, during which inhibition zones developed around the paper discs due to antimicrobial action. These zones were measured to evaluate the inhibition of bacterial growth [10]. Sterile water served as a control on pathogen-inoculated plates to confirm that any inhibitory effects observed were solely attributable to the antagonistic bacteria.
2.4. Physiological and Biochemical Characteristics of Antagonistic Bacteria
Antagonist bacteria were subjected to a series of tests to evaluate their physiological and biochemical reactions. These tests encompassed a range of important reactions, including Gram staining, starch hydrolysis, M.R (Methyl Red) test, glucose fermentation, sucrose fermentation, motility test, V.P (Voges–Proskauer) test, gelatin test, and citrate test, as outlined in [29].
2.5. Identification of Antagonist Bacterial Strains via Phylogenetic Examination of Their 16S rDNA Sequences
The bacterial strains were subjected to molecular identification through sequencing of the 16S rRNA gene segment. Genomic DNA extraction was performed using the Genomic DNA Kit from Urumqi Youkang Biotechnology Co., Ltd., Urumqi, China. Amplification of the 16S rRNA gene utilized the primer pair 27F (5′-AGAGTTTGATCCTGGCTCAG-3′) and 1492R (5′-GGTTACCTTGTTACGACTT-3′) [30]. PCR reactions were performed in a 20 μL volume according to the protocols outlined in [31], with slight modifications, specifying components and cycling conditions. Following successful amplification, DNA fragments were purified and sequenced by Urumqi Youkang Biotechnology Co., Ltd. The sequence data were uploaded to the NCBI database with reference numbers (PP453776.1 and OR511440.1) for comparative analysis with reference sequences. Phylogenetic analysis was conducted using the neighbor-joining (NJ) method with 1000 bootstrap iterations, implemented in MEGA 7.0 software. Sequence similarity calculations and multiple alignments were performed using Clustal W Mega 7.0. The phylogenetic relationships between Priestia and Bacillus strains were illustrated using neighbor-joining and MEGA 7.0, with 16S rDNA sequences as the dataset, supported by 1000 rounds of bootstrap resampling.
2.6. Identifying the Specific Genes Responsible for Producing Known Antimicrobial Substances
The screening process involved the utilization of specific primers for targeted genes, with PCR programs tailored to the individual annealing temperatures. The subsequent gel electrophoresis allowed for the observation and comparison of amplified DNA fragments, providing insights into the presence of gene targets related to antimicrobial compounds in the studied bacteria.
To detect the presence of gene targets associated with antimicrobial compounds in both B. subtilis and P. megaterium antagonist bacteria, PCR screening was conducted using specific primers outlined in (Table S1) [32,33]. The genes FenD, ItUc, YndJ, SrfAA, Spas, and QK1 were specifically targeted. The PCR program employed for this analysis featured an annealing temperature of 52 °C for fenD, ituC, and yndJ, while srfAA, Spas, and QK1 utilized temperatures of 62 °C, 58 °C, and 55 °C, respectively. Following the PCR reactions, the amplified products were separated on a 1.8% agarose gel in 0.5× Tris-borate EDTA (TBE) buffer for 2.5 h at 140 V. Visualization of the DNA bands was achieved by staining the gel with ethidium bromide. Size comparisons were conducted using a 5000 DNA marker provided by Nanjing Vazyme Biotech Company (Nanjing, China). Gel images were captured using an imaging system (Bio-Rad GelDoc EZ Gel Imaging System Thermo Fisher Scientific (Shanghai), Ltd., Shanghai, China).
2.7. Antibacterial Activity Observation
To initiate the experiment, a pure strain of the pear fire blight bacterium E. amylovora C1 was cultured, ensuring the logarithmic growth phase was reached. The bacterial concentration was adjusted to the desired level by measuring the optical density and diluting the suspension accordingly to OD600nm = 1 (approximately 1.0 × 108 CFU/mL). Nutrient agar medium was prepared by mixing beef extract, peptone, and NaCl, adjusting the pH to 7.2–7.4, and sterilizing via autoclaving. Agar plates were inoculated with 100 μL of bacterial suspension, ensuring an even distribution. Three holes were created in each plate using a sterile hole puncher, then 200 μL of antibacterial filtrate was added into the holes for treatment groups and sterile water for the control. Plates were incubated at 28 °C for 24 h for bacterial growth and inhibition zone development. The inhibition zone diameters were measured meticulously following established techniques referenced in [34]. Statistical analysis was performed to compare results between the antibacterial filtrate and the control. Conclusions were drawn from outcomes, highlighting implications for pear fire blight bacterium susceptibility to the antibacterial agent. Consistency was maintained through three replicates for each treatment to ensure robust data.
2.8. Assessing the Antibacterial Efficacy on Korla Fragrant Pear Leaves and Fruits
Potentially therapeutic and preventive activities of B. subtillis strain I2 and P. megaterium strain H1 against E. amylovora on detached pear tissues, such as leaves and fruits of the “Korla fragrant” pear, were investigated in the laboratory setting. To evaluate the effectiveness of the treatment, we used streptomycin. In order to evaluate the antibacterial properties of strains H1 and I2, we first used tap water to wash the removed leaves of the “Korla fragrant” pear. After being submerged in 3% bleach for 10 min, they were cleaned three times using sterile disinfected water (SDW). Using a syringe, we injected 100 μL of SDW into the intercellular gaps on the hollow petiole of mature leaves as a negative control. To maintain consistency, SDW was sprayed on all of the leaves [10,35].
The positive control was obtained by injecting 100 μL suspensions of pathogenic bacteria E. amylovora C1 (1.0 × 108 CFU/mL) in place of SDW, using the same technique. We sprayed the leaves with suspensions of antagonistic bacteria strains H1 and I2 (1.0 × 108 CFU/mL) and streptomycin solution separately after 48 h of incubation. The leaves were sprayed separately with streptomycin or strains H1 and I2 for protective tests. We injected 100 μL of pathogenic bacterial suspensions into the leaves after a further 48 h. We treated the leaves differently between the curative trials and the protective ones. We created a treatment control in which suspensions of strains H1 and I2 were sprayed onto leaves in order to observe the impact of the strains on the leaves. The suspensions of strains H1 and I2 were sprayed on the leaves once more after a 48 h period. After that, the treated leaves were put in a climate chamber at a temperature of 28 °C and a light-to-dark ratio (12:12 L:D), and symptoms were measured starting three to fifteen days after the inoculation (dpi). Three leaves were used in each treatment, and the trials were repeated three times. By calculating the percentage of leaf area impacted, the severity of the disease was determined [36]. Similarly, experimentation on pear fruits involved surface sterilization, maintenance in a sterile environment, and inoculation with either sterile water or a pathogenic cell suspension. Protective and curative assays were conducted using bacterial suspensions. Disease progression was monitored after 15 days using an infection index scale. The effectiveness of treatments was determined using the Abbott formula [36].
The disease severity (DS) is expressed as a percentage using the formula
where “a” represents the length of the blighted portion of the plant organ in centimeters, and “b” represents the total length of the plant organ in centimeters.
DS (%) = (a/b) × 100,
To determine the effectiveness (E) of the applications employed in the experiments, the Abbott formula is utilized and can be stated as follows:
where “E” denotes effectiveness, “K” represents the percentage disease severity of the control plant organ, and “U” represents the percentage disease severity of the treated plant organ.
E (%) = ((K − U)/K) × 100,
2.9. Antibiotic Sensitivity Test
A methodology was adopted using an NA medium to assess the susceptibility of P. megaterium and B. subtilis to eight antibiotics at a concentration of 30 μg/mL. The antibiotics chosen for the study were tetracycline, kanamycin, streptomycin, cefotaxime, erythromycin, ampicillin, penicillin, and ciprofloxacin. The antibiotics underwent sterilization by the process of filtering. Afterwards, 5 μL of each antibiotic solution was placed onto Whatman paper discs. These discs, infused with antibiotics, were placed strategically on the NA medium. The experimental setup underwent 24 h incubation at 28 °C to simulate optimal bacterial growth and antibiotic interaction conditions. Following incubation, the agar plates were inspected for observable phenomena [5]. The presence of inhibition zones around the paper discs indicated bacterial susceptibility to antibiotics, while their absence indicated resistance. This methodological framework, grounded in microbiological principles, offers insights into the antibiotic susceptibility of P. megaterium and B. subtilis compared to standard references as demonstrated in (Table S2) [37].
2.10. Growth Optimization of Isolates
We investigated various parameters affecting the growth dynamics of B. subtilis and P. megaterium. Initially, growth curves were constructed using a UV–Vis spectrophotometer to monitor the turbidity of nutrient broth cultures over time, elucidating temporal aspects of bacterial growth and interactions. Subsequently, we explored the temperature sensitivity of these bacteria across a range of temperatures (28 ± 2 °C to 36 ± 2 °C) in nutrient broth medium, identifying optimal growth conditions [38]. pH sensitivity was evaluated by culturing the bacteria in a nutrient broth medium across a pH range of 4 to 8, revealing their adaptability to varying pH levels. Furthermore, in vitro growth dynamics were examined by subjecting the bacterial cultures to different rpm values (150 to 210), indicating the impact of rotational speed on proliferation. Finally, we also assessed bacterial growth responses to varying inoculation amounts (1% to 4%) within the nutrient broth medium, providing insights into adaptive responses to different concentrations and environmental conditions [39,40]. These analyses contribute to a better understanding of the growth characteristics and environmental adaptability of B. subtilis and P. megaterium.
2.11. Thin-Layer Chromatography (TLC)
The thin-layer chromatography (TLC) technique, as outlined by [11], was employed to identify the antibacterial constituents within the extracted supernatant. Separation was achieved using a mixture of chloroform, methanol, and water (65:25:4, v/v/v), with visualization of spots accomplished by spraying the TLC plate with ninhydrin solution. The characterization of individual molecules was conducted through the calculation of their retention factor (Rf) values, with each experiment being replicated three times. The following lipopeptides were used as standard compounds: surfactin, iturins, bacillomycin D and fengycins. Table 1 provides specifics on how their corresponding retention factors (RF) were determined using TLC analysis [41,42].

Table 1.
List of RF values of various lipopeptides found in the TLC extract from H1 and I2.
3. Results
3.1. Identification of Bacterial Isolates
3.1.1. DNA-Based Identification
In the exploration of microbial diversity on apple and crabapple tree leaf surfaces, 10 bacterial specimens were isolated and screened for inhibitory potential against pathogens in vitro. Two strains displayed promising inhibitory activity. The 16S rRNA genes of these strains were partially sequenced, revealing a high similarity of 98–99% with known species in the GenBank database. (Figure 1A).

Figure 1.
(A) I6S rRNA gene PCR detection of P. megaterium H1 and B. subtilis I2. (B) Phylogenetic tree of partial 16S rRNA gene sequences of antagonistic bacteria along with the sequences from selected references strains. The analysis was conducted with MEGA 11 using a neighbor-joining method. Note: M: DL2000 DNA marker, H1: P. megaterium, I2: B. subtilis, NC: negative control.
Analysis of the nearly complete 16S rRNA gene sequences indicated a resemblance to those of P. megaterium and B. subtilis. Phylogenetic trees were constructed using a neighbor-joining method, illustrating the genetic relationships between the isolated strains and closely related bacteria (Figure 1B).
3.1.2. Characterization of Antagonistic Bacterial Species: Morphological, Physiological, and Biochemical Traits
The growth patterns of antagonist bacteria on the NA medium are depicted in Figure S1, while Table 2 provides a summary of the bacterium’s morphological, physiological, and biochemical features. The Gram staining technique demonstrates that both antagonistic bacteria have a Gram-positive nature and a rod-shaped morphology. This is evident from the white-coloured colonies observed (Figure S1). In addition, both bacterial isolates exhibited motility and tested positive for glucose, catalase, gelatin liquefaction, and starch hydrolysis. Both isolates exhibited a negative reaction in the MR (Methyl Red) test, while displaying a positive result in the V.P (Voges-Proskauer) test.

Table 2.
Results of morphological and biochemical tests on isolates of P. megaterium H1 and B. subtilis I2.
3.2. Antibiotic Sensitivity Test
The antibiotic resistance of both antagonistic bacteria was evaluated using the disk-diffusion method. As shown in (Figure 2A,B), the results show moderate sensitivity of P. megaterium H1 to erythromycin and moderate sensitivity of B. subtilis I2 to both erythromycin and ciprofloxacin. Additionally, both antagonistic bacteria exhibited susceptibility to ampicillin, penicillin, cefotaxime, kanamycin, streptomycin, and tetracycline.
Figure 2.
Antibiotic sensitivity test result of isolate (A) P. megaterium H1 and (B) B. subtilis I2. Note: Cif, ciprofloxacin; A, ampicillin; E, erythromycin; P, penicillin. C, cefotaxim; K, kanamycin; T, tetracycline; S, streptomycin.
3.3. Factors Affecting Antagonistic Bacterial Growth Sensitivity Analysis
Both antagonistic bacteria, B. subtilis strain I2 and P. megaterium H1, grow well between pH 5 and 7, with a maximum OD600 value of 1.561 at pH 5 for B. subtilis I2 and 2.029 for P. megaterium H1 (Figure 3A). When the inoculum amount is 3%, the maximum OD600 value is 2.031 for P. megaterium H1 and 2.112 for B. subtilis strain I2, which is the optimal inoculum amount (Figure 3C). Different temperatures have a greater impact on the growth of both antagonistic bacteria. The maximum OD600 value is 2.068 at 34 °C for B. subtilis I2 and 2.028 at 30 °C for P. megaterium H1, which is the optimal growth temperature for both (Figure 3B). There are certain differences in the OD600 values under different shaker speed conditions. In the range of 150–210 r/min, the OD600 value continues to increase with the increase of the rotation speed. When the rotation speed is 210 r/min, the maximum OD600 value is 2.165 for B. subtilis I2, but for P. megaterium H1, 150 r/min is determined to be the optimal rotation speed because its maximum OD600 value at this rotation speed is 2.028 (Figure 3D).

Figure 3.
Effect of four different factors ((A) temperature, (B) pH, (C) inoculum size, (D) rotation speed) on the growth of antagonistic bacteria B. subtilis I2, P. megaterium H1 after 24 h of incubation. Error bars presented are the mean ± standard deviation of triplicates of three independent experiments. Different letters shows significant difference (p = 0.05).
3.4. Growth Curve of Antagonist Bacteria
The growth curves of the antagonist bacteria B. subtilis strain I2 and P. megaterium H1, monitored over a total period of 18 h with measurements taken at 2 h intervals, exhibited typical bacterial growth dynamics, consisting of lag, exponential, and stationary phases. For the H1 strain, the lag phase persisted for the initial 4 h, followed by a rapid increase in growth during the exponential phase, which extended from 4 to 12 h. By the end of the exponential phase, the growth rate began to slow down, indicative of the approaching stationary phase, which continued until the end of the observation period. Similarly, the I2 strain demonstrated a lag phase lasting for the initial 6 h, followed by an exponential growth phase extending from 6 to 14 h. Subsequently, the growth rate slowed, transitioning into the stationary phase, which persisted until the end of the monitoring period. These observations illustrate the characteristic growth dynamics of bacterial populations, highlighting distinct phases in their growth patterns over time (Figure S2).
3.5. In Vitro Antagonistic Activity of B. subtilis I2 and P. megaterium H1 against E. amylovora
Ten bacterial strains were obtained from apple and crabapple plants. Out of these, two strains shown strong antagonistic activity against E. amylovora using the plate confrontation method (Figure 4A). The range of the inhibition zone diameters was between 15.95 ± 0.65 and 25.90 ± 0.25 mm. B. subtilis I2 exhibited significantly greater inhibitory activity against E. amylovora compared to P. megaterium H1. The inhibition zone diameter of B. subtilis I2 was measured at 25.90 ± 0.25 mm (Figure 4B), while P. megaterium H1 had a smaller diameter of 15.95 ± 0.65 mm. These two strains were chosen for additional analysis and identification.

Figure 4.
Screening and inhibition of E. amylovora by antagonistic bacteria. (A) The effect of antagonistic bacteria against E. amylovora, B. subtilis I2, P. megaterium H1, NC: Negative control (B) Diameter of antagonistic inhibition zone of antagonist strains. Different letters shows significant difference (p = 0.05).
3.6. Identifying the Specific Genes Responsible for Producing Known Antimicrobial Substances
PCR amplification was conducted on the DNA of antagonistic bacteria B. subtilis I2 and P. megaterium H1 targeting six antibiotic-related genes from Bacillus and Prietia. Positive PCR results were exclusively obtained for three antimicrobial genes common to both bacterial strains, as elaborated and depicted in (Figure 5A–C). Among the detected genes, iturin synthesis gene ituC, fengycin synthesis gene fenD, and subtilin synthesis gene QK1 were identified. However, genes srfAA, YndJ, and Spas were not detected in this study. This suggests a distinct genetic makeup and antimicrobial potential between the strains, highlighting the variability in antibiotic gene expression among antagonistic bacteria.

Figure 5.
PCR gel electrophoresis of the QK1, ItUc, and FenD antibiotic synthesis genes. Note: (A) fenD, (B) ituC, (C) QK1. M: DL5000 DNA marker, 1: P. megaterium H1, 2: B. subtilis I2, NC: negative control.
3.7. Antibacterial Filtrate Activity
The antibacterial activity of P. megaterium H1 and Bacillus subtilis against E. amylovora was evaluated using the disk-diffusion method. Results show that the cell-free supernatant of both P. megaterium H1 and Bacillus subtilis displayed antimicrobial efficacy in comparison to bacterial cell disruption (Figure S3). This observation suggests that the antimicrobial activity can be attributed to the extracellular secondary metabolites secreted by P. megaterium H1 and Bacillus subtilis I2.
3.8. Efficacy of Bacterial Antagonists on Detached Pear Fruits and Leaves
The results showed significant reductions in disease symptoms and pathogen proliferation in fruit treated with strains of B. subtilis I2 and P. megaterium H1, comparable to the effectiveness of streptomycin. These strains exhibited a notable reduction in fruit infection, with B. subtilis I2, P. megaterium H1, and streptomycin reducing infection by 53.39%, 44.76%, and 49.69%, respectively (Figure 6A and Figure 7A,B).

Figure 6.
Protective and curative effects of B. subtilis I2 and P. megaterium H1 against Erwinia amylovora on detached pear leaves (A) and fruits (B) after 15 days post-inoculation (dpi). The leaves and fruits were collected from “Korla fragrant” pear.

Figure 7.
Disease severity and effectiveness of B. subtilis I2, P. megaterium H1, and the commonly used chemical compound (streptomycin) against E. amylovora. (A,B) fruits and (C,D) leaves. NC, negative control; PC, positive. Means with the same letter are not significantly different at p ≤ 0.05.
Similarly, in detached pear leaf experiments, thorough disinfection preceded treatments with bacterial suspensions or streptomycin. Observations over a 15-day period revealed significant reductions in foliar disease symptoms and pathogen proliferation in leaves treated with strains P. megaterium H1 and B. subtilis I2. B. subtilis I2 and P. megaterium H1 demonstrated high efficacy comparable to streptomycin, with reductions in foliar infection by 59.55%, 55.53%, and 56.69%, respectively (Figure 6B and Figure 7C,D). These findings underscore the potential of B. subtilis I2 and P. megaterium H1 as effective biological control agents against fire blight, offering promising alternatives to chemical interventions.
Significantly reduced symptoms of disease and pathogen development were seen in pear tissues treated with B. subtilis I2 and P. megaterium H1 in all in vivo experiments, compared to the positive control (p < 0.05). Moreover, the efficacy of protective and curative treatments using B. subtilis I2 and P. megaterium H1 against E. amylovora were comparable to that of streptomycin, suggesting their potential as biological control agents for managing fire blight.
3.9. Analyzing Lipopeptides with TLC
Thin-layer chromatography (TLC) was employed for the separation and preliminary identification of lipopeptides within methanol extracts, utilizing ninhydrin solution spray for visualization. Lipopeptides such as fengycins, iturins, bacillomycin D, and surfactins were successfully separated and identified using this method.
To identify the compounds responsible for inhibiting the growth of E. amylovora, methanol extracts of lipopeptides derived from the antagonistic bacteria B. subtilis I2 and P. megaterium H1 were analyzed by TLC. The analysis revealed four active compounds from both strains, which exhibited inhibitory effects on E. amylovora growth. Two of these active compounds were found in both B. subtilis I2 and P. megaterium H1, displaying Rf values consistent with iturin- and surfactin-like lipopeptides (0.56 to 0.64). Additionally, bacillomycin D (Rf 0.35) was identified in B. subtilis I2, while fengycins (Rf 0.43) were detected in P. megaterium H1 (Figure 8A,B). The findings corroborate previous reports by [41,42].

Figure 8.
(A) The antibacterial activity analysis of organic extracts from P. megaterium strain H1 and B. subtilis strain I2 against E. amylovora on an NA medium. (B) Separation of active compounds by thin-layer chromatography (TLC). EM, extracted with methanol.
4. Discussion
The fragrant pear industry in Xinjiang, China, faces significant challenges stemming from the proliferation of pests and diseases such as pear scab, rust, black spot, and fire blight. Controlling pear fire blight poses significant challenges due to the resilient nature and wide dispersion of E. amylovora as well as the diverse range of tissues it infects. Currently, there is no singularly effective chemical or control method for this disease [43]. Traditional approaches involve pruning affected branches and applying copper-based compounds or antibiotics like streptomycin and oxytetracycline [5,44]. However, these methods have limitations; pruning may be ineffective in severe cases, while excessive copper application can lead to plant toxicity and yield reduction. Prolonged antibiotic use also carries the risk of bacterial resistance and environmental contamination. As a result, there is growing interest in biological control methods as promising alternatives. These approaches leverage natural agents or mechanisms to suppress the growth and spread of E. amylovora. By harnessing biological control agents such as antagonistic microbes or bacteriophages, researchers aim to develop sustainable strategies that minimize environmental impact and reduce the risk of resistance development. This shift towards biological control reflects a recognition of the limitations and drawbacks associated with conventional chemical treatments, signaling a proactive effort to explore innovative solutions for managing pear fire blight effectively [10,45].
In recent years, challenges in the fragrant pear industry have been exacerbated by various factors, including extensive planting, dependence on a narrow range of cultivars, and frequent international fruit trade. The combined effects of these factors have significantly impeded the sustainability and productivity of the fragrant pear industry [46].
During the initial phase, in the orchards situated in Korla, Xinjiang, distinctive symptoms of dark brown wilting were noted on the tender shoots of pear trees. These symptoms bore a resemblance to those typically associated with pear fire blight. In efforts to pinpoint the causative agent responsible for this manifestation, bacterial samples were carefully isolated from the affected branches and subjected to thorough identification procedures.
In this study, we isolated 10 distinct bacteria from both apple and crabapple leaves, and identified two strains that exhibited antagonistic behavior against E. amylovora, the causative agent of fire blight. Using a combination of 16S rRNA analysis, biochemical assays, and microscopy, the antagonistic bacteria were classified as Bacillus and Priestia species. Notably, B. subtilis strain I2 displayed the most potent antagonistic activity against E. amylovora. Subsequent in vitro experiments evaluated the protective and therapeutic efficacy of P. megaterium H1 and B. subtilis strain I2 on pear tree tissue. The findings demonstrated that both strains effectively mitigated pear fire blight infections in leaves and fruits. Furthermore, the protective application of the antagonistic bacteria was more effective in preventing infection compared to therapeutic intervention. These results highlight the potential of these bacterial strains as biocontrol agents for managing fire blight in pear orchards.
While there is not much data on the ability of P. megaterium and B. subtilis to suppress fire blight in pears, new research has investigated their potential as biocontrol agents. P. megaterium and B. subtilis were injected onto the leaves and fruits of solitary pear trees in experiments to evaluate their efficacy in protective and therapeutic roles. According to the data, both bacterial species showed promise in lowering the frequency of fire blight, with protective treatment producing better results than therapeutic intervention. Notably, B. subtilis strain I2 has shown great promise as a biocontrol agent for controlling pear orchard fire blight. These results highlight the potential of B. subtilis and P. megaterium as effective fire blight control agents in pear orchards.
Studies has showed that Bacillus species are effective against plant infections because they produce antimicrobial chemicals [47]. Bacillus species are capable of synthesizing many bioactive compounds, including non-ribosomal peptides, lipopeptides, polyketides, siderophores, and bacteriocins [48]. Bacillus produces lipopeptides, which can be classified into three main families: fengycins, surfactins, and iturins [49]. Iturins have strong antifungal effects against various types of yeast and filamentous fungi, but their antibacterial effects are limited. Fengycins have effective antifungal activity, especially against filamentous fungi, and recent studies suggest they also have antibacterial properties [50]. Sur-factins are known for their significant bactericidal activity [51]. The disease control achieved with lipopeptides involves both direct interaction with the biological membranes of bacterial and fungal pathogens and indirect stimulation of systemic resistance in plants [52]. P. megaterium and B. subtilis strains generate a wide range of bioactive lipopeptides, such as surfactins, lichenysin, iturin A, and fengycins A and B [53,54].
In this study, both the cell-free supernatant and methanol extract derived from P. megaterium H1 and B. Subtilis I2 exhibited antibacterial properties, indicating the secretion of bioactive compounds, potentially secondary metabolites, with hydrophobic characteristics. TLC analysis revealed the presence of lipopeptides in the methanol extract, as evidenced by the formation of a blue-purple substance from P. megaterium H1, with corresponding RF values of 0.231, 0.430, 0.569, and 0.641, while for B. subtilis I2, they were 0.251, 0.271, 0.359, 0.541, and 0.630. These RF values imply that the methanol extract contains lipopeptides (surfactins, iturins, bacillomycin D, and fengycins), consistent with prior research [11,42,55].
PCR results were obtained exclusively for three antimicrobial genes common to both antagonistic bacteria, which produce the subtilin, fengycin, and iturin A found in the methanol extract. These lipopeptides possess antibacterial, antifungal, and antiviral activities, suggesting their potential application in the prevention and treatment of pear fire blight [32].
This study found that P. megaterium strain H1 and B. subtilis strain I2 effectively inhibited the growth of E. amylovora on detached pear leaves and fruits. However, additional research is required to examine the effectiveness of strain H1 and I2 in combating fire blight disease in natural environmental settings. In conclusion, the broad-spectrum antagonistic activity exhibited by P. megaterium H1 and B. subtilis I2 makes them potential bacteria for the development of novel biocontrol agents to combat fire blight disease.
5. Conclusions
The current study identified two out of ten distinct bacteria isolated from the leaves of apple and crabapple plants that exhibited antagonistic behavior toward E. amylovora, the pathogen responsible for fire blight in pears. These bacteria, namely P. megaterium H1 and B. subtilis I2, were found to release unique peptide antibiotics, such as fengycin, subtilin, and iturin A, into the environment to inhibit the activity of E. amylovora C1. Further analysis revealed the presence of several antibacterial substances, including surfactin, iturins, bacillomycin D, and fengycins, in the methanol extract obtained from these two antagonistic bacteria using TLC. This finding suggests the potential these bacteria and their antibiotic compounds have in controlling fire blight disease in pear orchards.
Supplementary Materials
The following supporting information can be downloaded at: https://www.mdpi.com/article/10.3390/microorganisms12050896/s1. Table S1. primers used to detect gene for biological control in B. subtilis and P. megaterium. Table S2. Chart outlining interpretive standards for zone diameter, used to determine the sensitivity and resistance status of antibiotics through the disk diffusion method. Figure S1. Streaking and pure NB agar plate of Isolate (A). P. megaterium H1, (B). B. subtilis I2. Morphology of (C). P. megaterium H1 (D). B. subtilis I2 light-microscope photomicrograph showing the rod form. Figure S2. Antagonist bacteria growth curve in different intervals. Figure S3. (A): Screening and inhibition of E. amylovora by antagonistic bacteria filtrate. (B): Diameter of inhibition zone of antagonist strains filtrate.
Author Contributions
L.S. conceived and designed the study. I.u.D. and L.H. performed most of the experiments and drafted the manuscript. Y.J. and J.W. helped perform some experiments. M.A. helped analyze data and revise the manuscript. All authors have read and agreed to the published version of the manuscript.
Funding
This work was supported by Technologies R & D Program of Bingtuan (Grant Number 2023AB004-03).
Institutional Review Board Statement
The study was approved by the Institutional Review Board of the College of Life Sciences, Shihezi University, Xinjiang, China (grant number 2023AB004-03 and 6 March 2024).
Informed Consent Statement
Not applicable.
Data Availability Statement
Data are contained within the article and Supplementary Materials.
Acknowledgments
We are very thankful to our lab research group for providing the reference strain used in this study.
Conflicts of Interest
The authors declare that the research was conducted in the absence of any commercial or financial relationships that could be construed as a potential conflict of interest.
References
- Moreau, M.; Degrave, A.; Vedel, R.; Bitton, F.; Patrit, O.; Renou, J.-P.; Barny, M.-A.; Fagard, M. EDS1 contributes to nonhost resistance of Arabidopsis thaliana against Erwinia amylovora. Mol. Plant-Microbe Interact. 2012, 25, 421–430. [Google Scholar] [CrossRef] [PubMed]
- Mayer, M.; Oberhuber, C.; Loncaric, I.; Heissenberger, B.; Keck, M.; Scheiner, O.; Hoffmann-Sommergruber, K. Fireblight (Erwinia amylovora) affects Mal d 1-related allergenicity in apple. Eur. J. Plant Pathol. 2011, 131, 1–7. [Google Scholar] [CrossRef]
- Dean, R.; Van Kan, J.A.; Pretorius, Z.A.; Hammond-Kosack, K.E.; Di Pietro, A.; Spanu, P.D.; Rudd, J.J.; Dickman, M.; Kahmann, R.; Ellis, J. The Top 10 fungal pathogens in molecular plant pathology. Mol. Plant Pathol. 2012, 13, 414–430. [Google Scholar] [CrossRef] [PubMed]
- Malnoy, M.; Martens, S.; Norelli, J.L.; Barny, M.-A.; Sundin, G.W.; Smits, T.H.; Duffy, B. Fire blight: Applied genomic insights of the pathogen and host. Annu. Rev. Phytopathol. 2012, 50, 475–494. [Google Scholar] [CrossRef] [PubMed]
- Slama, H.B.; Cherif-Silini, H.; Chenari Bouket, A.; Qader, M.; Silini, A.; Yahiaoui, B.; Alenezi, F.N.; Luptakova, L.; Triki, M.A.; Vallat, A. Screening for Fusarium antagonistic bacteria from contrasting niches designated the endophyte Bacillus halotolerans as plant warden against Fusarium. Front. Microbiol. 2019, 9, 3236. [Google Scholar] [CrossRef] [PubMed]
- Koczan, J.M.; Lenneman, B.R.; McGrath, M.J.; Sundin, G.W. Cell surface attachment structures contribute to biofilm formation and xylem colonization by Erwinia amylovora. Appl. Environ. Microbiol. 2011, 77, 7031–7039. [Google Scholar] [CrossRef] [PubMed]
- Persen, U.; Gottsberger, R.; Reisenzein, H. Spread of Erwinia amylovora in apple and pear trees of different cultivars after artificial inoculation. In Proceedings of the XII International Workshop on Fire Blight 896, Warsaw, Poland, 20 August 2010; pp. 319–330. [Google Scholar]
- McManus, P.S.; Stockwell, V.O.; Sundin, G.W.; Jones, A.L. Antibiotic use in plant agriculture. Annu. Rev. Phytopathol. 2002, 40, 443–465. [Google Scholar] [CrossRef]
- Pandey, S.; Giri, K.; Kumar, R.; Mishra, G.; Raja Rishi, R. Nanopesticides: Opportunities in crop protection and associated environmental risks. Proc. Natl. Acad. Sci. India Sect. B Biol. Sci. 2018, 88, 1287–1308. [Google Scholar] [CrossRef]
- Vanneste, J.; Cornish, D.; Spinelli, F.; Yu, J. Colonisation of apple and pear leaves by different strains of biological control agents of fire blight. N. Z. Plant Prot. 2004, 57, 49–53. [Google Scholar] [CrossRef]
- Chen, X.-H.; Scholz, R.; Borriss, M.; Junge, H.; Mögel, G.; Kunz, S.; Borriss, R. Difficidin and bacilysin produced by plant-associated Bacillus amyloliquefaciens are efficient in controlling fire blight disease. J. Biotechnol. 2009, 140, 38–44. [Google Scholar] [CrossRef]
- Broggini, G.A.; Duffy, B.; Holliger, E.; Schärer, H.-J.; Gessler, C.; Patocchi, A. Detection of the fire blight biocontrol agent Bacillus subtilis BD170 (Biopro®) in a Swiss apple orchard. Eur. J. Plant Pathol. 2005, 111, 93–100. [Google Scholar] [CrossRef]
- Roselló, M.; Peñalver, J.; Llop, P.; Gorris, M.T.; Cambra, M.; López, M.; Chartier, R.; García, F.; Montón, C. Identification of an Erwinia sp. different from Erwinia amylovora and responsible for necrosis on pear blossoms. Can. J. Plant Pathol. 2006, 28, 30–41. [Google Scholar] [CrossRef]
- Sharifazizi, M.; Harighi, B.; Sadeghi, A. Evaluation of biological control of Erwinia amylovora, causal agent of fire blight disease of pear by antagonistic bacteria. Biol. Control 2017, 104, 28–34. [Google Scholar] [CrossRef]
- Cabrefiga, J.; Montesinos, E. Lysozyme enhances the bactericidal effect of BP100 peptide against Erwinia amylovora, the causal agent of fire blight of rosaceous plants. BMC Microbiol. 2017, 17, 39. [Google Scholar] [CrossRef]
- Cabrefiga, J.; Bonaterra, A.; Montesinos, E. Mechanisms of antagonism of Pseudomonas fluorescens EPS62e against Erwinia amylovora, the causal agent of fire blight. Int. Microbiol. 2007, 10, 123. [Google Scholar] [CrossRef]
- Tancos, K.; Villani, S.; Kuehne, S.; Borejsza-Wysocka, E.; Breth, D.; Carol, J.; Aldwinckle, H.; Cox, K. Prevalence of streptomycin-resistant Erwinia amylovora in New York apple orchards. Plant Dis. 2016, 100, 802–809. [Google Scholar] [CrossRef] [PubMed]
- Mercier, J.; Lindow, S. Field performance of antagonistic bacteria identified in a novel laboratory assay for biological control of fire blight of pear. Biol. Control 2001, 22, 66–71. [Google Scholar] [CrossRef]
- McGhee, G.C.; Sundin, G.W. Evaluation of kasugamycin for fire blight management, effect on nontarget bacteria, and assessment of kasugamycin resistance potential in Erwinia amylovora. Phytopathology 2011, 101, 192–204. [Google Scholar] [CrossRef]
- Kamber, T.; Buchmann, J.P.; Pothier, J.F.; Smits, T.H.; Wicker, T.; Duffy, B. Fire blight disease reactome: RNA-seq transcriptional profile of apple host plant defense responses to Erwinia amylovora pathogen infection. Sci. Rep. 2016, 6, 21600. [Google Scholar] [CrossRef]
- Shibata, T.; Ishimaru, K.; Kawaguchi, S.; Yoshikawa, H.; Hama, Y. Antioxidant activities of phlorotannins isolated from Japanese Laminariaceae. In Proceedings of the Nineteenth International Seaweed Symposium, Kobe, Japan, 26–31 March 2007; pp. 255–261. [Google Scholar]
- Stockwell, V.; Johnson, K.; Sugar, D.; Loper, J. Control of fire blight by Pseudomonas fluorescens A506 and Pantoea vagans C9-1 applied as single strains and mixed inocula. Phytopathology 2010, 100, 1330–1339. [Google Scholar] [CrossRef]
- Ongena, M.; Jourdan, E.; Adam, A.; Paquot, M.; Brans, A.; Joris, B.; Arpigny, J.L.; Thonart, P. Surfactin and fengycin lipopeptides of Bacillus subtilis as elicitors of induced systemic resistance in plants. Environ. Microbiol. 2007, 9, 1084–1090. [Google Scholar] [CrossRef] [PubMed]
- Lehman, S.M. Development of a Bacteriophage-Based Biopesticide for Fire Blight. Ph.D. Thesis, Brock University, St. Catharines, ON, Canada, 2007. [Google Scholar]
- Cui, Z.; Sun, L. Isolation and characterization of Priestia megaterium KD7 for the biological control of pear fire blight. Front. Microbiol. 2023, 14, 1099664. [Google Scholar] [CrossRef] [PubMed]
- Gromyko, O.; Tistechok, S.; Roman, I.; Aravitska, O.; Luzhetskyy, A.; Parnikoza, I.; Fedorenko, V. Isolation and characterization of culturable actinobacteria associated with Polytrichum strictum (Galindez Island, the maritime Antarctic). Ukr. Antarct. J. 2021, 1, 82–97. [Google Scholar] [CrossRef]
- Avelar Ferreira, P.A.; Bomfeti, C.A.; Lima Soares, B.; de Souza Moreira, F.M. Efficient nitrogen-fixing Rhizobium strains isolated from amazonian soils are highly tolerant to acidity and aluminium. World J. Microbiol. Biotechnol. 2012, 28, 1947–1959. [Google Scholar] [CrossRef] [PubMed]
- Mitra, D.; Mondal, A.K.; Mukhopadhyay, A. Unique level of Multi-Drug Resistance (MDR) in Pseudomonas aeruginosa strain DEB1. Int. J. Sci Res 2014, 3, 455–460. [Google Scholar] [CrossRef]
- Chauhan, A.; Jindal, T.; Chauhan, A.; Jindal, T. Biochemical and molecular methods for bacterial identification. In Microbiological Methods for Environment, Food and Pharmaceutical Analysis; Springer: Cham, Switzerland, 2020; pp. 425–468. [Google Scholar] [CrossRef]
- Turner, S.; Pryer, K.M.; Miao, V.P.; Palmer, J.D. Investigating deep phylogenetic relationships among cyanobacteria and plastids by small subunit rRNA sequence analysis 1. J. Eukaryot. Microbiol. 1999, 46, 327–338. [Google Scholar] [CrossRef] [PubMed]
- Kim, J.; Rohlf, F.J.; Sokal, R.R. The accuracy of phylogenetic estimation using the neighbor-joining method. Evolution 1993, 47, 471–486. [Google Scholar] [CrossRef]
- Joshi, R.; McSpadden Gardener, B.B. Identification and characterization of novel genetic markers associated with biological control activities in Bacillus subtilis. Phytopathology 2006, 96, 145–154. [Google Scholar] [CrossRef]
- Hu, X.; Fang, Q.; Li, S.; Wu, J.; Chen, J. Isolation and characterization of endophytic and rhizosphere bacterial antagonists of soft rot pathogen from Pinellia ternata. FEMS Microbiol. Lett. 2009, 295, 10–16. [Google Scholar] [CrossRef]
- Balouiri, M.; Sadiki, M.; Ibnsouda, S.K. Methods for in vitro evaluating antimicrobial activity: A review. J. Pharm. Anal. 2016, 6, 71–79. [Google Scholar] [CrossRef]
- Zeng, Q.; Sundin, G.W. Genome-wide identification of Hfq-regulated small RNAs in the fire blight pathogen Erwinia amylovora discovered small RNAs with virulence regulatory function. BMC Genom. 2014, 15, 414. [Google Scholar] [CrossRef] [PubMed]
- Gür, A.; Baştaş, K.K. Effectiveness of Phosphorous acid, Bacillus subtilis and Copper Compounds on Apple cv. Gala with M9 Rootstock in the Control of Fire Blight. Turk. J. Agric.-Food Sci. Technol. 2023, 11, 2595–2600. [Google Scholar] [CrossRef]
- Wayne, P. Performance Standards for Antimicrobial Disc Susceptibility Testing; National Committee for Clinical Laboratory Standards: Wayne, PA, USA, 2002; Volume 12, pp. 1–53. [Google Scholar] [CrossRef]
- Ross, T.; Zhang, D.; McQuestin, O.J. Temperature governs the inactivation rate of vegetative bacteria under growth-preventing conditions. Int. J. Food Microbiol. 2008, 128, 129–135. [Google Scholar] [CrossRef] [PubMed]
- Li, M.; Chen, X.; Bu, H.; Liao, L.; Li, J.; Zhang, N.; Shi, F. Isolation, Identification and Biocontrol Potential of Antagonistic Fungi against Zanthoxylum bungeanum Root Rot. Chin. J. Biol. Control 2023, 39, 176. [Google Scholar] [CrossRef]
- Yang, E.; Fan, L.; Yan, J.; Jiang, Y.; Doucette, C.; Fillmore, S.; Walker, B. Influence of culture media, pH and temperature on growth and bacteriocin production of bacteriocinogenic lactic acid bacteria. AMB Express 2018, 8, 10. [Google Scholar] [CrossRef] [PubMed]
- Meena, K.R.; Tandon, T.; Sharma, A.; Kanwar, S.S. Lipopeptide antibiotic production by Bacillus velezensis KLP2016. J. Appl. Pharm. Sci. 2018, 8, 091–098. [Google Scholar] [CrossRef]
- Soussi, S.; Essid, R.; Hardouin, J.; Gharbi, D.; Elkahoui, S.; Tabbene, O.; Cosette, P.; Jouenne, T.; Limam, F. Utilization of grape seed flour for antimicrobial lipopeptide production by Bacillus amyloliquefaciens C5 strain. Appl. Biochem. Biotechnol. 2019, 187, 1460–1474. [Google Scholar] [CrossRef] [PubMed]
- Klee, S.M.; Sinn, J.P.; McNellis, T.W. The apple fruitlet model system for fire blight disease. In Plant Innate Immunity: Methods and Protocols; Humana: New York, NY, USA, 2019; pp. 187–198. [Google Scholar] [CrossRef]
- Tamura, K.; Dudley, J.; Nei, M.; Kumar, S. MEGA4: Molecular evolutionary genetics analysis (MEGA) software version 4.0. Mol. Biol. Evol. 2007, 24, 1596–1599. [Google Scholar]
- Mannaa, M.; Kim, K.D. Biocontrol activity of volatile-producing Bacillus megaterium and Pseudomonas protegens against Aspergillus and Penicillium spp. predominant in stored rice grains: Study II. Mycobiology 2018, 46, 52–63. [Google Scholar] [CrossRef]
- Brewer, L.; Palmer, J. Global pear breeding programmes: Goals, trends and progress for new cultivars and new rootstocks. In Proceedings of the XI International Pear Symposium 909, Patagonia, Argentina, 23–26 November 2010; pp. 105–119. [Google Scholar]
- Shafi, J.; Tian, H.; Ji, M. Bacillus species as versatile weapons for plant pathogens: A review. Biotechnol. Biotechnol. Equip. 2017, 31, 446–459. [Google Scholar] [CrossRef]
- Iqbal, S.; Begum, F.; Rabaan, A.A.; Aljeldah, M.; Al Shammari, B.R.; Alawfi, A.; Alshengeti, A.; Sulaiman, T.; Khan, A. Classification and multifaceted potential of secondary metabolites produced by Bacillus subtilis group: A comprehensive review. Molecules 2023, 28, 927. [Google Scholar] [CrossRef] [PubMed]
- Théatre, A.; Hoste, A.; Rigolet, A.; Benneceur, I.; Bechet, M.; Ongena, M.; Deleu, M.; Jacques, P. Bacillus sp.: A remarkable source of bioactive lipopeptides. In Biosurfactants for the Biobased Economy; Springer: Cham, Switzerland, 2022; pp. 123–179. [Google Scholar]
- Villegas-Escobar, V.; González-Jaramillo, L.M.; Ramírez, M.; Moncada, R.N.; Sierra-Zapata, L.; Orduz, S.; Romero-Tabarez, M. Lipopeptides from Bacillus sp. EA-CB0959: Active metabolites responsible for in vitro and in vivo control of Ralstonia solanacearum. Biol. Control 2018, 125, 20–28. [Google Scholar] [CrossRef]
- Fan, H.; Zhang, Z.; Li, Y.; Zhang, X.; Duan, Y.; Wang, Q. Biocontrol of bacterial fruit blotch by Bacillus subtilis 9407 via surfactin-mediated antibacterial activity and colonization. Front. Microbiol. 2017, 8, 1973. [Google Scholar] [CrossRef] [PubMed]
- Falardeau, J.; Wise, C.; Novitsky, L.; Avis, T.J. Ecological and mechanistic insights into the direct and indirect antimicrobial properties of Bacillus subtilis lipopeptides on plant pathogens. J. Chem. Ecol. 2013, 39, 869–878. [Google Scholar] [CrossRef] [PubMed]
- Pueyo, M.T.; Bloch, C.; Carmona-Ribeiro, A.M.; Di Mascio, P. Lipopeptides produced by a soil Bacillus megaterium strain. Microb. Ecol. 2009, 57, 367–378. [Google Scholar] [CrossRef] [PubMed]
- Wang, T.; Liang, Y.; Wu, M.; Chen, Z.; Lin, J.; Yang, L. Natural products from Bacillus subtilis with antimicrobial properties. Chin. J. Chem. Eng. 2015, 23, 744–754. [Google Scholar] [CrossRef]
- Tunio, A.A.; Naqvi, S.H.; REHMAN, T.; Bhutto, M.A.; MUGHERİ, M.H. Determination of Antioxidant, Antimicrobial Properties with Evaluation of Biochemicals and Phytochemicals Present in Oscillatoria limosa of District Jamshoro, Pakistan. Yuz. Yıl Univ. J. Agric. Sci. 2022, 32, 538–547. [Google Scholar] [CrossRef]
Disclaimer/Publisher’s Note: The statements, opinions and data contained in all publications are solely those of the individual author(s) and contributor(s) and not of MDPI and/or the editor(s). MDPI and/or the editor(s) disclaim responsibility for any injury to people or property resulting from any ideas, methods, instructions or products referred to in the content. |
© 2024 by the authors. Licensee MDPI, Basel, Switzerland. This article is an open access article distributed under the terms and conditions of the Creative Commons Attribution (CC BY) license (https://creativecommons.org/licenses/by/4.0/).